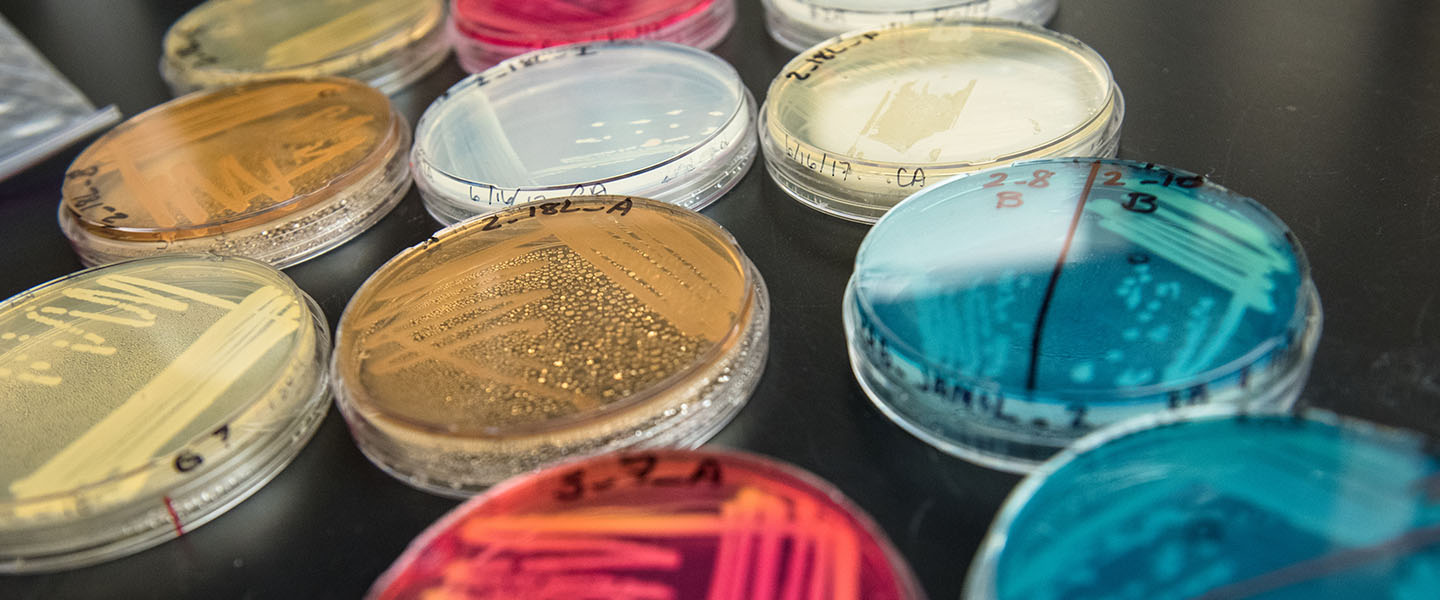
Close up of petri dishes

Graduation Success Rate
College of
Arts & Sciences
The College develops women and men for others, ready to face the intellectual, vocational and spiritual challenges of today and tomorrow.

Welcome to the College of Arts & Sciences
A Message from the Dean, Annmarie Caño.
I welcome you to the College of Arts and Sciences, please know that there are many people—fellow students, faculty, staff, and alumni—who are also welcoming you into this community. May you enjoy your time with us!
Read more here.

Recent Stories
In Honor and Memory of Fr. Steve Kuder, SJ
How you can join the family and friends of Fr. Steve Kuder, SJ, in honoring his memory.
Murdock grant to help new Gonzaga U. biology professor
A $25,400 grant from the M.J. Murdock Charitable Trust will help a new biology professor at...
Tim Szarnicki: In Service from Coast-to-Coast
Since graduating Gonzaga in 2008, Tim Szarnicki has stayed true to his simple mission: to help...
CAS 2019 Graduate Success Rate
92.6%
252
Employed After Graduation
36
Volunteering Service
81
Continuing Their Education






